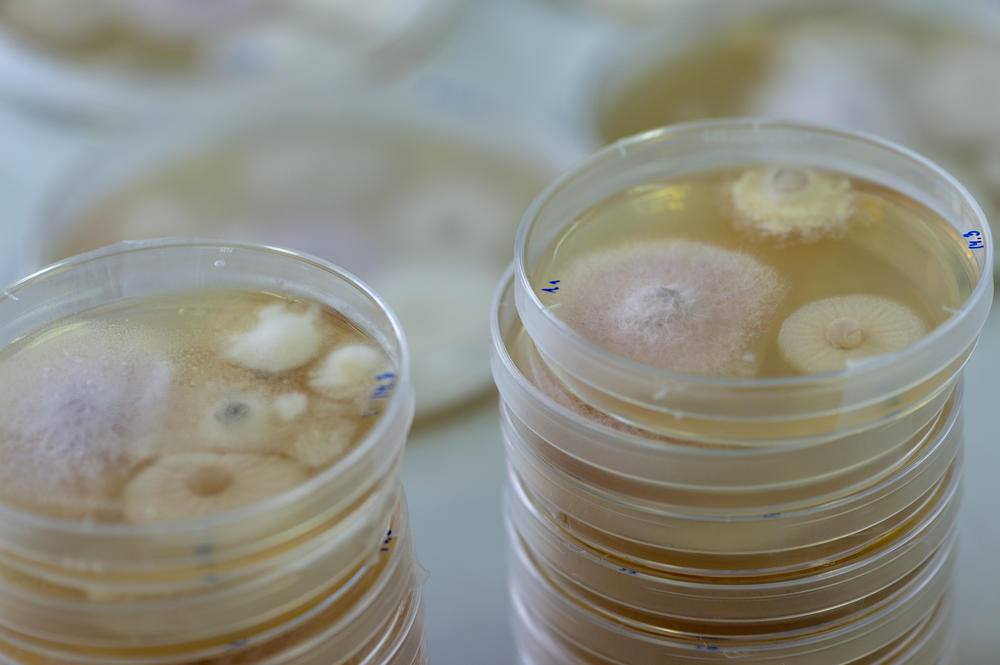

White Cabbage Butterfly at Home Alone
How plants, animals, and fungi at Freie Universität are being cared for during minimal on-site period
Apr 20, 2020
Cabbage white butterflies are bred at the Institute of Biology to investigate how plants defend themselves against caterpillar feeding. The butterflies are still being cared for, even though the experiments had to be interrupted.
Image Credit: Bernd Wannenmacher
In order to curb the spread of the coronavirus, Freie Universität Berlin has been operating with a minimal on-site presence since March 23. Academic and non-academic staff are working at home, and laboratory experiments have been shut down. But fungi, insects, and plants live in the labs and greenhouses on campus and have to be cared for. Campus.leben spoke with several staff members at the Department of Biology, Chemistry, Pharmacy and the Department of Veterinary Medicine on behalf of many other committed employees who maintain emergency operations there.
“We have to take care of horseradish leaf beetles, elm leaf beetles, cabbage white butterflies, and common pine sawflies,” says Johanna Schott, a doctoral student in biology who works in the group of Applied Zoology / Animal Ecology headed by Professor Monika Hilker. Among other things, they conduct research on how plants defend themselves against insect pests. “The associated forage plants, various types of cabbage, watercress, and small elm trees also need care. And every now and then we harvest fresh pine branches for the sawflies.”
Everyone helps. Even the secretary was trained in the care of animal and plant breeding so that she can step in in case of an emergency, says Johanna Schott. There are three teams of three people each on different days of the week, and there are several substitutes for each team. To communicate, the group uses email, the telephone, messenger apps, and video conferences.
“In the spring we usually get additional elm leaf beetles from France. Then the main season for experiments begins,” says Johanna Schott. That will probably be difficult this year. Except for caring for the insects on hand, all the lab work had to be interrupted, and samples from experiments that had already been conducted could not be processed. “That is a problem for doctoral students who rely on the results of the experiments to complete their doctoral thesis,” says Schott. “At the moment, we are concentrating on paperwork that is possible to do from home.”
Switch to Theoretical Topics
“The whole situation is a huge challenge,” says biologist Matthias Rillig. “We are mainly an experimental laboratory. We investigate living organisms.” Rillig, a professor of ecology, investigates how soils react to an increasing number of influences caused by humans and supervises the work of many students and graduate students who are affected by the closed labs. “We are looking for individual solutions, but this takes a lot of time and energy.”
Some of the doctoral researchers were able to switch their focus to theoretical topics or data analysis, according to Rillig. However, there are serious difficulties with projects that rely on sampling in the field. In some cases the progress will be delayed by an entire plant growth period.
There are also various types of live inventory in Matthias Rillig's lab: plants, fungi cultures, and animals that live in soil, such as springtails, nematodes (threadworms), and mites. That was easy to take care of. Rillig pointed out that they started preparing for the crisis early on and shut down quite a few of the experiments to avoid losses. Some experiments, such as long-term studies on the evolution of fungi, were literally able to be frozen.
Beehives in Dahlem, Düppel, and Spandau
This type of solution wasn't possible for the bee colonies at Freie Universität because a busy phase is just beginning for their caregivers. Benedikt Polaczek, a master of beekeeping at the Institute of Veterinary Biochemistry at Freie Universität, is responsible for the five beehives that are in the garden of the Institute of Biology. There are constant buzzing and humming sounds: The bees have been breeding since January and have just reached the maximum brood volume. Soon they will want to swarm: The old queen leaves the nest with part of the bee population to make room for a young successor. Benedikt Polaczek says that at the very latest by Easter he will need to stop by each hive at least once a week to prevent the swarming. As soon as he sees signs that they are ready, he will take the old queen with around 10,000 bees and place them in a new beehive.
The bees have been breeding since January and have just reached the maximum brood volume.
Image Credit: Anja Matys
The two apprentices Polaczek is currently training have been temporarily released from work due to the Covid 19 pandemic, so he not only has to regularly inspect the beehives in Dahlem, but also in Düppel and Spandau himself. “Just recently, I noticed that a young queen was laying her eggs in the wrong cells,” he said. As a result, the survival of the entire population was at stake. Fortunately, he was able to intervene in time and appoint a new queen.
The next few weeks will be stressful because soon honey will be ready to be extracted and Polaczek has to prepare a digital version of his lecture on beekeeping. He is confident that he can do it. After all, living things have to be cared for, even if research is at a standstill.
The Animals Don't Notice That There Is a Covid 19 Pandemic
At the Department of Veterinary Medicine at Freie Universität, operations are almost normal in many areas because the clinics are systemically relevant and therefore still open and treating their patients. These are the Small Animal Clinic, the Equine Clinic, the Ruminant and Swine Clinic, the Institute of Poultry Diseases, and the Clinic of Animal Reproduction.
Especially in the Small Animal Clinic there are a lot of people and pets coming and going – following strict precautionary measures to avoid spreading infection –, because dog and cat owners take seriously ill pets to the clinic. In addition, animals with very serious illnesses are also taken in and cared for on site in the animal hospital.
Professor Uwe Rösler, vice dean for research and managing director of the Institute of Animal and Environmental Hygiene, pointed out that all of the clinics and institutes have two or more teams that work alternately. The Department of Veterinary Medicine wants to keep the clinics running for as long as possible. If one team is affected by quarantine due to Covid 19, the other team can take over. That also means that everyone who is there has to work a lot more than usual.
The colleagues in the laboratories for clinical diagnostics as well as diagnostics for food safety and animal pathology will continue to work with this team solution, even after the corona crisis abates.
Not only animal patients have to be cared for. Cows, horses, sheep, goats, pigs, dogs, turkeys, chickens, and alpacas that are used for training veterinary students live on campus. “The animals don't even notice that there is a Covid 19 pandemic,” says Uwe Rösler. “They have the right to be looked after as well as always.” According to the Animal Welfare Act, every owner has to take care of his or her animals at least once a day and make sure they are well and healthy. “We feed and check them twice a day, sometimes more often.” However, new animals are not currently being added, as the Department doesn't want to aggravate the tense situation for the employees. Just as on a farm, the animals have to be cared for even on holidays, and now in particular, over the long Easter weekend.
The original German version of this article was published on April 9, 2020, in campus.leben, the online magazine of Freie Universität Berlin.
Further Information
The Botanic Garden, which is part of Freie Universität Berlin, has also been closed to the public and affected by reduced on-site operations due to the corona pandemic. But the plants and gardens need to be cared for. Biologist Gesche Hohlstein, who is responsible for press and public relations at the Botanic Garden, described what is being done behind the scenes. (in German)
Due to the Covid 19 pandemic, the beekeeping courses offered by the Institute for Veterinary Biochemistry in conjunction with the Berlin-Zehlendorf beekeepers association cannot take place in the 2020 summer semester.